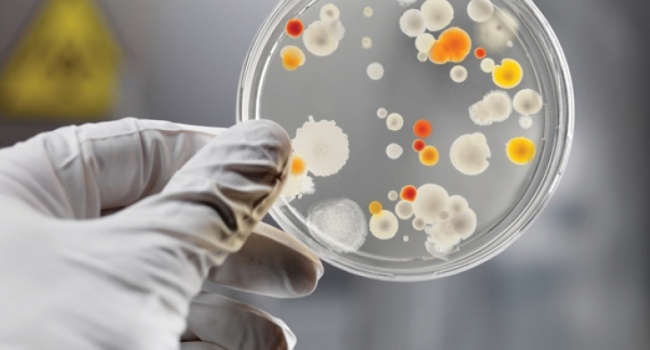
����� ������� �������� �� ������� ����

2017-8-17 15:45 |
В инфекционной больнице Кривого Рога сразу у четырнадцати пациентов диагностировали вирус Коксаки, и в настоящий момент все заболевшие проходят стационарное лечение. Как информирует replyua. net со ссылкой на krivbass.
city, вспышки вируса Коксаки на сегодняшний день были зафиксированы уже в нескольких регионах Украины: в Сумах, в Чертковском районе Тернопольской области и в.
Подробнее читайте на replyua.net ...




